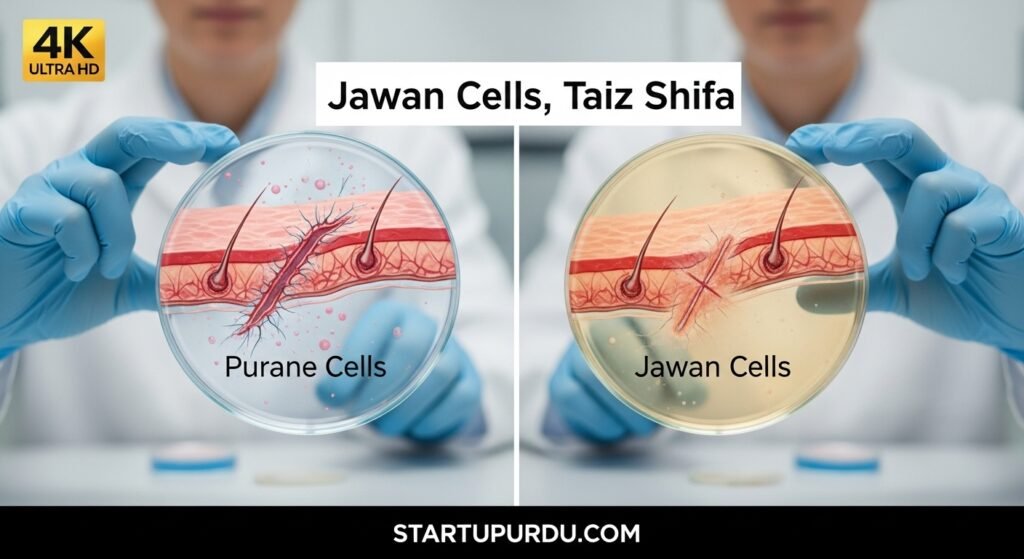
Scientists Reverse Aging in Human Skin Cells by 30 Years

Barhti umar (aging) ek aisa qudrati amal hai jise hamesha na-qabil-e-shikast (invincible) samjha jaata raha hai. Lekin kya ho agar science waqt ke is (wheel) ko aahista, ya shayad ulat, ghumanay ka tareeqa dhoond le? Babraham Institute ke scientists ne haal hi mein ek aisi tareekhi kamyabi haasil ki hai jisne anti-aging research ki duniya mein تہلکہ (stir) macha diya hai. Unhon ne insani jild ke khuliyat (cells) ko “reprogram” kar ke unki molecular (salamati) umar mein taqreeban 30 saal ki kami kar di hai. Yeh tehqeeq mustaqbil mein umar kam karne ka tareeqa ijaad karne ki taraf ek ahem qadam hai.
The Science of Turning Back Time (Waqt Ko Peechay Le Janay Ki Science)
Is inqilabi tehqeeq ki bunyad “Yamanaka factors” par hai. Yeh chaar khaas qisam ke proteins hain jo kisi bhi aam jismaani khuliye (cell) ko wapas stem cell ki ibtidai (initial) halat mein le ja sakte hain. Lekin is baar, scientists ne is amal ko poora nahi kiya. Unhon ne “partial reprogramming” ka tareeqa apnaya.
Unhon ne ek 53-sala shakhs ke jild ke khuliyat liye aur un par 50 dinon ke bajaye, sirf 13 dinon ke liye Yamanaka factors ka istemal kiya. Nateeja hairan kun tha: khuliyat apni asal shanakht (identity), yaani jild ke khuliyat, to barqarar rakhe hue thay, lekin unki tamam biological alamaat (markers) 30 saal puranay jism ke khuliyat jaisi ho gayi theen. Yani, woh ab ek 23-sala shakhs ke khuliyat ki tarah kaam kar rahe thay.
What Did the “Younger” Cells Do? (In “Jawan” Cells Ne Kya Kiya?)
Yeh tabdeeli sirf sathi (superficial) nahi thi. In “jawan” kiye gaye khuliyat ne apni karkardagi (performance) mein bhi numayan behtari dikhayi:
- Zyada Collagen Ki Paidawar: Unhon ne collagen (woh protein jo jild ko lachakdar aur jawan rakhta hai) ki paidawar barha di. Collagen production kaise barhayein ka yeh ek bilkul naya jawab ho sakta hai.
- Taiz Shifa (Faster Healing): Jab in khuliyat ko lab mein ek “zakham” diya gaya, to unhon ne puranay khuliyat ke muqablay mein bohat zyada tezi se us zakham ko bhar diya.
Yeh is baat ka saboot hai ke yeh khuliyat sirf dikhne mein nahi, balke kaam mein bhi jawan ho gaye thay.
What This Means for the Future of Aging (Barhti Umar Ke Mustaqbil Ke Liye Iska Kya Matlab Hai?)
Is tehqeeq ke mumkina (potential) asraat bohat wasee hain aur yeh sirf jhurriyan (wrinkles) khatam karne tak mehdood nahi. Mustaqbil mein, is technology ko in maqasid ke liye istemal kiya ja sakta hai:
- Behtar Shifa: Barhay hue logon mein zakhmon ke bharne ki raftaar ko taiz karna.
- Umar Se Munsalik Beemariyan: Jild ki un beemarion ka ilaaj jo umar ke sath barhti hain.
- Regenerative Medicine: Jism ke deegar hisson, jese ke pathon (muscles) ya joron (joints), ko bhi “jawan” karne ke liye is tareeqay par tehqeeq ki ja sakti hai.

A Long Road Ahead: Hope and Caution (Abhi Manzil Door Hai: Umeed aur Ehtiyat)
Is tamam shandaar khabar ke bawajood, yeh yaad rakhna zaroori hai ke yeh tehqeeq abhi apne ibtidai marhalay mein hai. Yeh tajarbaat (experiments) abhi sirf lab mein kiye gaye hain aur inhein insanon par aazmana abhi baqi hai. Scientists ko pehle is (method) ke mehfooz (safe) honay ko yaqeeni banana hoga. Is liye, agarche umeed bohat hai, lekin ehtiyat ka daman hath se nahi chhorna chahiye.
Lekin ek baat tay hai: yeh daryaft umar ke barhne ke amal ko samajhne aur usay control karne ki insani justuju (quest) mein ek tareekhi sang-e-meel (milestone) hai.



